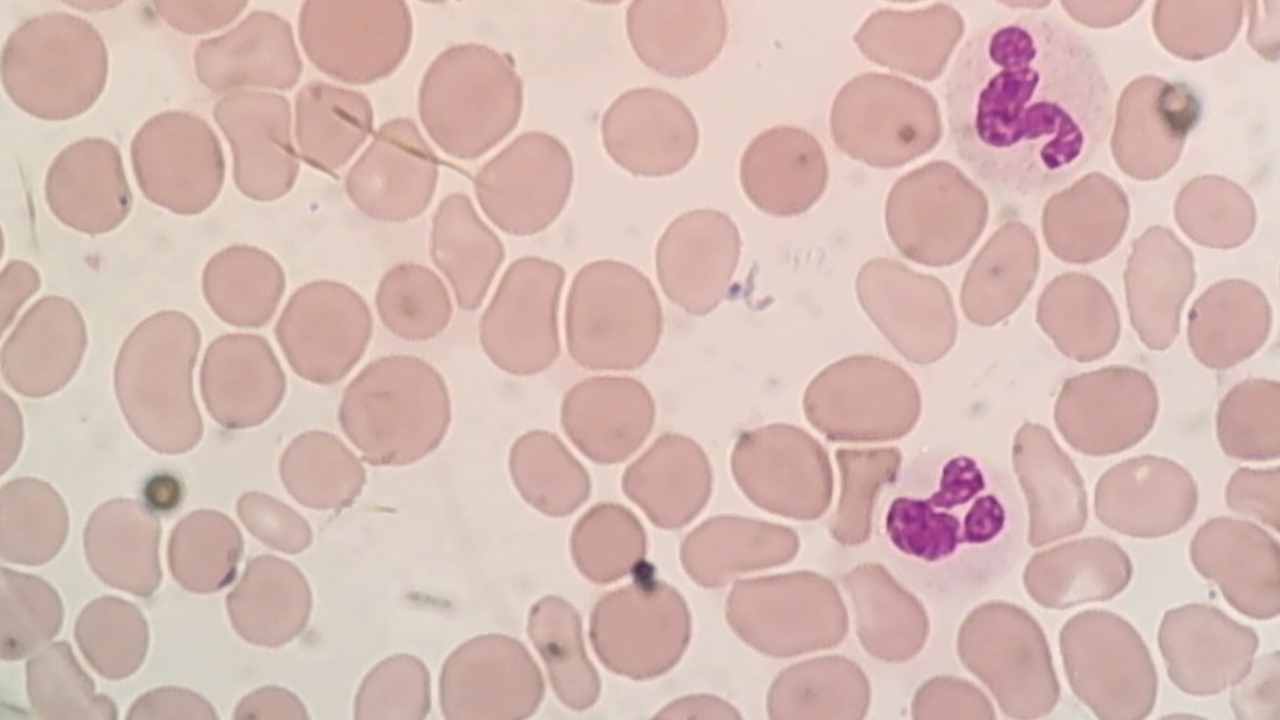

我有以下类型的图像(血细胞):
是否有模式识别算法,可以检测血细胞?
发布于 2014-05-15 20:33:50
OpenCV库包括一个Hough算法,它允许在图像中查找圆圈。
发布于 2014-05-15 21:45:26
发布于 2014-05-15 23:01:28
在你发布的图片中,看起来最强烈的信号是:红细胞的颜色,它们的边缘,以及它们是大小大致相同的斑点。
下面的简单算法可能有效。你可以谷歌如何在OpenCV或MATLAB或任何你正在使用的东西做这些事情。
如果上面的方法不够好,你可能需要做一个更先进的方法,基于强亮度梯度倾向于指向远离红细胞中心的事实。“我的瞳孔探测”项目中的pdf讨论了如何做到这一点:https://github.com/LukeAllen/optimeyes。
https://stackoverflow.com/questions/23615380
复制相似问题